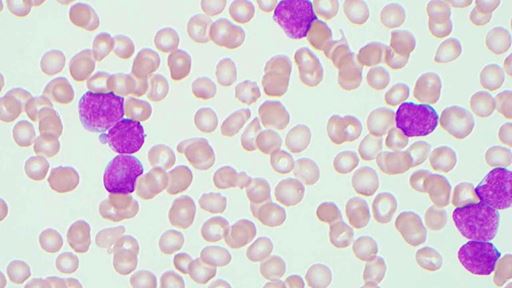
Team discovers how to target 'undruggable' protein that fuels aggressive leukemia

CAP in the News
The Member mentions page highlights media coverage of CAP Fellows, who speak on behalf of themselves or their institutions. Please feel free to share this page or any of the individual stories with your colleagues or post to your social media. If you have any questions we encourage you to contact Media Relations and Editorial Manager Angela Panateri.